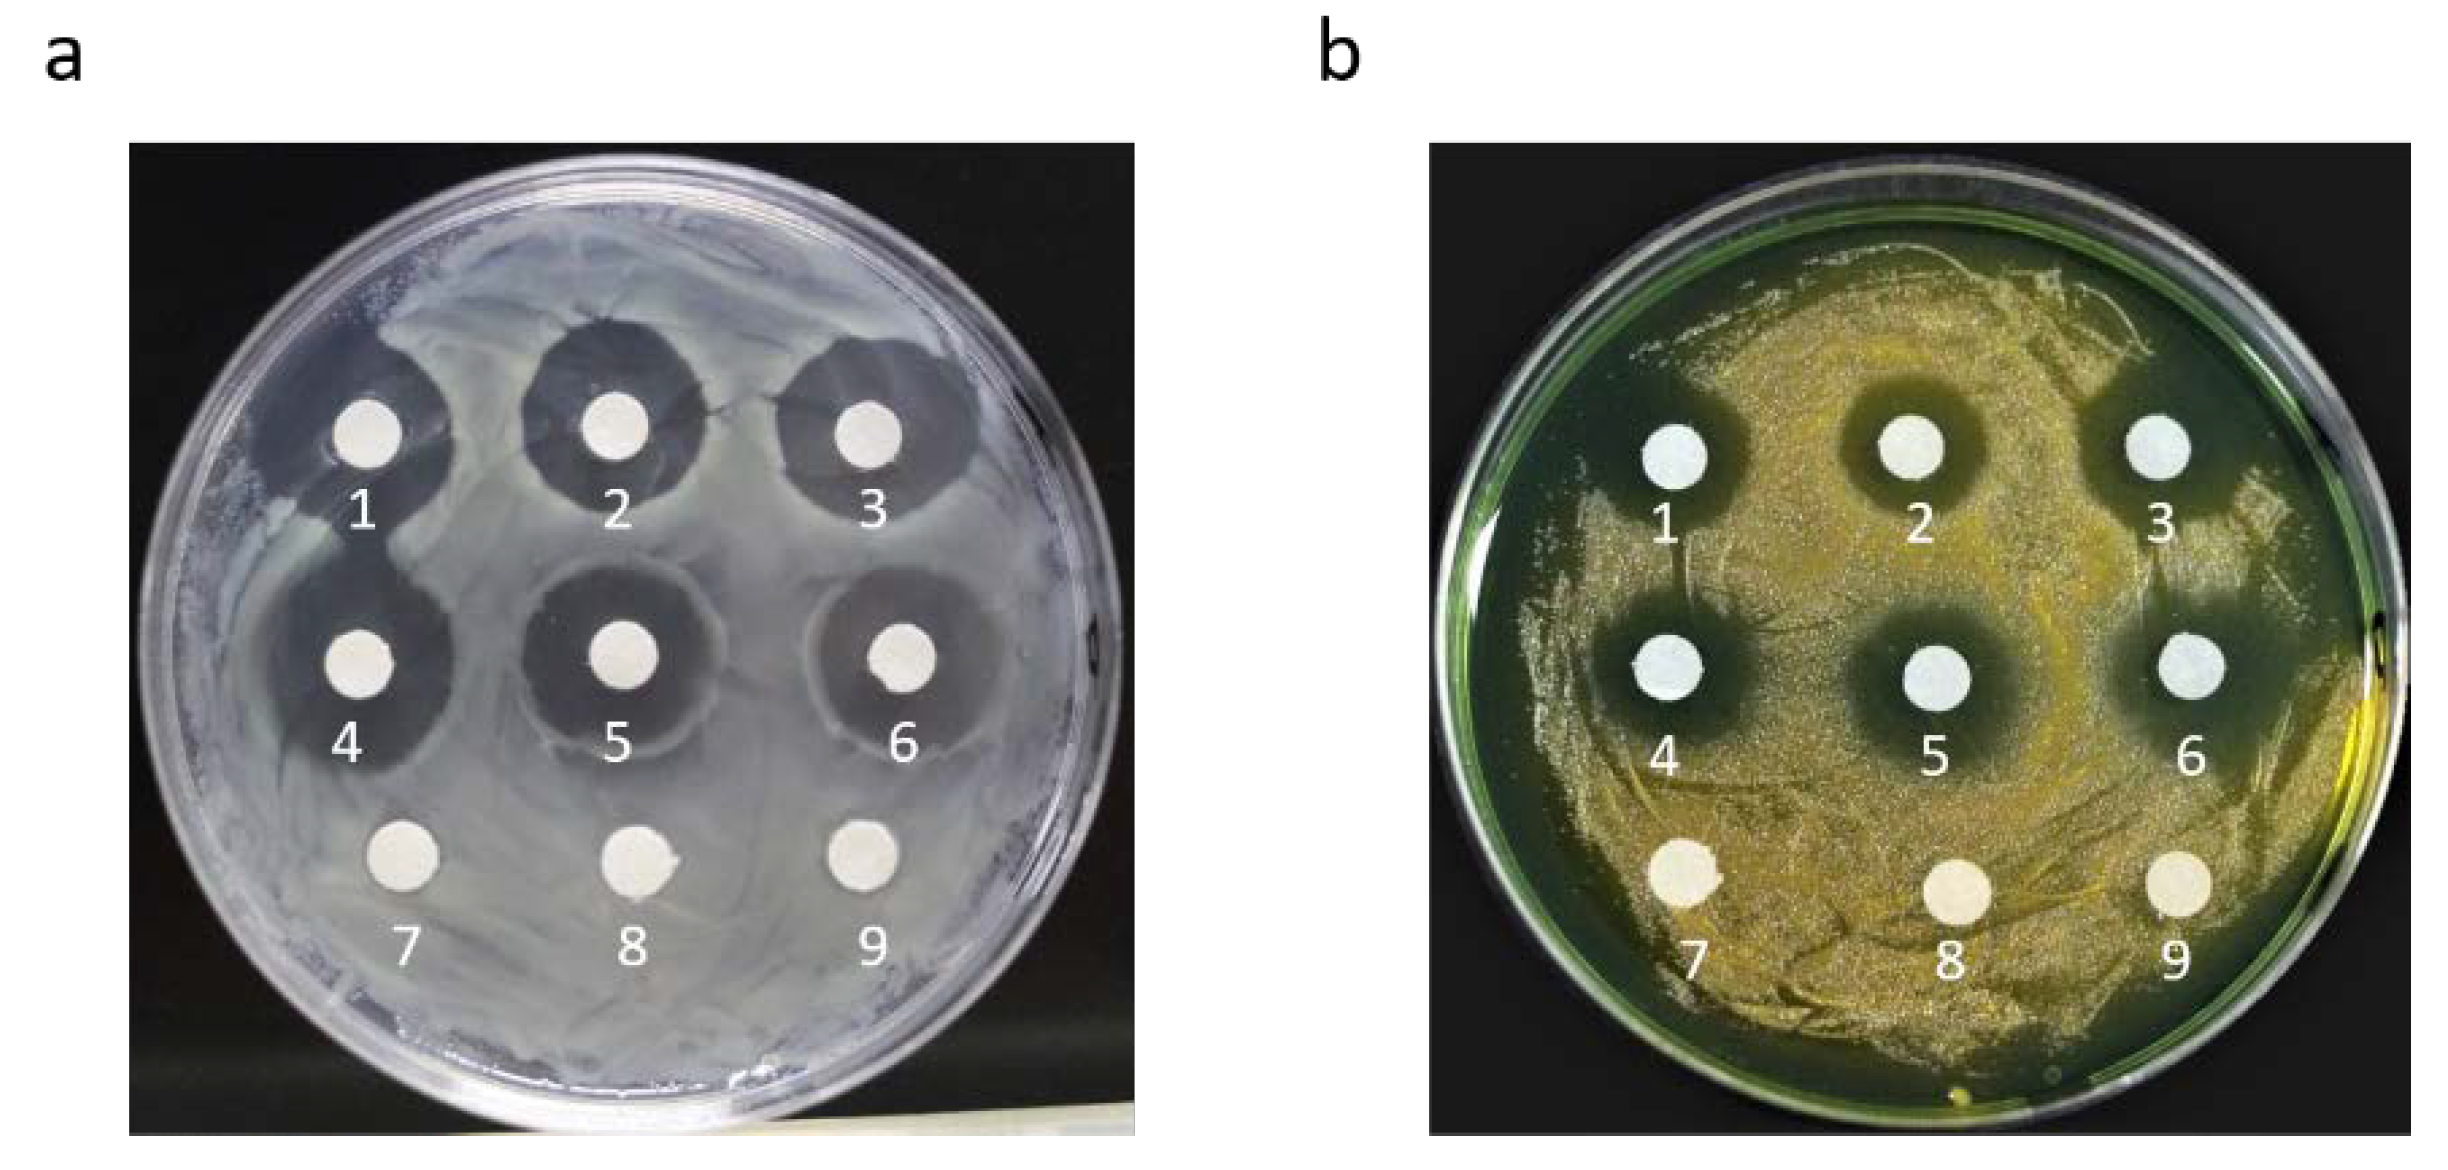
Marinedrugs 20 00484 g003

Two Foreign Antimicrobial Peptides Expressed in the Chloroplast of Porphyridium purpureum Possessed Antibacterial Properties
Abstract
1. Introduction
2. Results
2.1. Construction of Chloroplast Transformation Vector for Porphyridium purpureum Containing a Polycistron Expressing Two AMP Genes
2.2. Two AMPs Were Expressed in the Chloroplast of P. purpureum
2.3. The Recombinant AMPs from Crude Protein Extract Possessed Significant Antimicrobial Activity
3. Discussion
3.1. Chloroplast Expression System Has Significant Advantages
3.2. Microalgae Can Serve as Good Protein Bioreactors
3.3. Expression of Recombinant AMPs in P. purpureum Has Excellent Application Prospects
3.4. Protein Expression Still Need to Be Improved
4. Materials and Methods
4.1. Strain and Growth Conditions
4.2. Construction of the Chloroplast Expression Vector
4.3. Biolistic Transformation and Selection of Transformed Strains
4.4. Molecular Identification of Transformed Strains
4.5. Determination of Antibacterial Activity of Recombinant AMPs in Crude Protein Extracts
5. Conclusions
Author Contributions
Funding
Institutional Review Board Statement
Data Availability Statement
Acknowledgments
Conflicts of Interest
References
- Dadar, M.; Dhama, K.; Vakharia, V.N.; Hoseinifar, S.H.; Karthik, K.; Tiwari, R.; Khandia, R.; Munjal, A.; Salgado-Miranda, C.; Joshi, S.K. Advances in Aquaculture Vaccines Against Fish Pathogens: Global Status and Current Trends. Rev. Fish. Sci. Aquac. 2016, 25, 184–217. [Google Scholar] [CrossRef]
- Nayak, A.; Karunasagar, I.; Chakraborty, A.; Maiti, B. Potential application of bacteriocins for sustainable aquaculture. Rev. Aquac. 2021, 14, 1234–1248. [Google Scholar] [CrossRef]
- Ma, P.; Wu, Y.; Jiang, W.; Shao, N.; Zhou, M.; Chen, Y.; Xie, J.; Qiao, Z.; Liu, R. Biodegradable peptide polymers as alternatives to antibiotics used in aquaculture. Biomater. Sci. 2022. [Google Scholar] [CrossRef]
- Charoonnart, P.; Purton, S.; Saksmerprome, V. Applications of Microalgal Biotechnology for Disease Control in Aquaculture. Biology 2018, 7, 24. [Google Scholar] [CrossRef]
- Pérez-Sánchez, T.; Mora-Sánchez, B.; Balcázar, J.L. Biological Approaches for Disease Control in Aquaculture: Advantages, Limitations and Challenges. Trends Microbiol. 2018, 26, 896–903. [Google Scholar] [CrossRef] [PubMed]
- Zhang, C.; Yang, M. Antimicrobial Peptides: From Design to Clinical Application. Antibiotics 2022, 11, 349. [Google Scholar] [CrossRef] [PubMed]
- Lei, J.; Sun, L.; Huang, S.; Zhu, C.; Li, P.; He, J.; Mackey, V.; Coy, D.H.; He, Q. The antimicrobial peptides and their potential clinical applications. Am. J. Transl. Res. 2019, 11, 3919–3931. [Google Scholar]
- Xiong, Y.Q.; Hady, W.A.; Deslandes, A.; Rey, A.; Fraisse, L.; Kristensen, H.-H.; Yeaman, M.R.; Bayer, A.S. Efficacy of NZ2114, a Novel Plectasin-Derived Cationic Antimicrobial Peptide Antibiotic, in Experimental Endocarditis Due to Methicillin-Resistant Staphylococcus aureus. Antimicrob. Agents Chemother. 2011, 55, 5325–5330. [Google Scholar] [CrossRef]
- Liu, C.-W.; Su, B.-C.; Chen, J.-Y. Tilapia Piscidin 4 (TP4) Reprograms M1 Macrophages to M2 Phenotypes in Cell Models of Gardnerella vaginalis-Induced Vaginosis. Front. Immunol. 2021, 12, 5123. [Google Scholar] [CrossRef]
- Puangpee, S.; Suanyuk, N. In vitro and in vivo evaluation of antimicrobial activity of Zooshikella marina against pathogenic bacteria causing vibriosis in aquaculture. Aquac. Res. 2021, 52, 4996–5007. [Google Scholar] [CrossRef]
- Andes, D.; Craig, W.; Nielsen, L.A.; Kristensen, H.H. In Vivo Pharmacodynamic Characterization of a Novel Plectasin Antibiotic, NZ2114, in a Murine Infection Model. Antimicrob. Agents Chemother. 2009, 53, 3003–3009. [Google Scholar] [CrossRef] [PubMed]
- Mygind, P.H.; Fischer, R.L.; Schnorr, K.M.; Hansen, M.T.; Sönksen, C.P.; Ludvigsen, S.; Raventós, D.; Buskov, S.; Christensen, B.; De Maria, L.; et al. Plectasin is a peptide antibiotic with therapeutic potential from a saprophytic fungus. Nature 2005, 437, 975–980. [Google Scholar] [CrossRef]
- Park, N.G.; Silphaduang, U.; Moon, H.S.; Seo, J.-K.; Corrales, J.; Noga, E.J. Structure−Activity Relationships of Piscidin 4, a Piscine Antimicrobial Peptide. Biochemistry 2011, 50, 3288–3299. [Google Scholar] [CrossRef] [PubMed]
- Lu, J.; Zhang, Y.; Wu, J.; Wang, J. Intervention of antimicrobial peptide usage on antimicrobial resistance in aquaculture. J. Hazard. Mater. 2021, 427, 128154. [Google Scholar] [CrossRef] [PubMed]
- Zhang, Y.; Li, Z.; Li, L.; Rao, B.; Ma, L.; Wang, Y. A Method for Rapid Screening, Expression, and Purification of Antimicrobial Peptides. Microorganisms 2021, 9, 1858. [Google Scholar] [CrossRef] [PubMed]
- Zhan, N.; Wang, T.; Zhang, L.; Shan, A. A eukaryotic expression strategy for producing the novel antimicrobial peptide PRW4. Braz. J. Microbiol. 2020, 51, 999–1008. [Google Scholar] [CrossRef]
- Roldán-Tapia, M.; Anné, J.; Reyes, A.G.; Carrasco, U.; Millán-Pacheco, C.; Barrios-González, J.; Mejía, A. Streptomyces as Overexpression System for Heterologous Production of an Antimicrobial Peptide. Protein Pept. Lett. 2017, 24, 483–488. [Google Scholar] [CrossRef][Green Version]
- Rojas, V.; Rivas, L.; Cárdenas, C.; Guzmán, F. Cyanobacteria and Eukaryotic Microalgae as Emerging Sources of Antibacterial Peptides. Molecules 2020, 25, 5804. [Google Scholar] [CrossRef]
- Li, S.; Ji, L.; Shi, Q.; Wu, H.; Fan, J. Advances in the production of bioactive substances from marine unicellular microalgae Porphyridium spp. Bioresour. Technol. 2019, 292, 122048. [Google Scholar] [CrossRef]
- Bayu, A.; Noerdjito, D.R.; Rahmawati, S.I.; Putra, M.Y.; Karnjanakom, S. Biological and technical aspects on valorization of red microalgae genera Porphyridium. Biomass Convers. Biorefinery 2022, 1–17. [Google Scholar] [CrossRef]
- Kavitha, M.D.; Shree, M.H.S.; Vidyashankar, S.; Sarada, R. Acute and subchronic safety assessment of Porphyridium purpureum biomass in the rat model. J. Appl. Phycol. 2015, 28, 1071–1083. [Google Scholar] [CrossRef]
- Huang, J.; Chen, B.; Liang, S. Analysis of the Nutritional Composition in Porphyridium Cruentum. Food Ferment. Ind. 2005, 31, 105–106. [Google Scholar]
- Ng, I.-S.; Tan, S.; Kao, P.; Chang, Y.; Chang, J. Recent Developments on Genetic Engineering of Microalgae for Biofuels and Bio-Based Chemicals. Biotechnol. J. 2017, 12, 1600644. [Google Scholar] [CrossRef] [PubMed]
- Gangl, D.; Zedler, J.A.Z.; Rajakumar, P.D.; Martinez, E.M.R.; Riseley, A.; Włodarczyk, A.; Purton, S.; Sakuragi, Y.; Howe, C.J.; Jensen, P.E.; et al. Biotechnological exploitation of microalgae. J. Exp. Bot. 2015, 66, 6975–6990. [Google Scholar] [CrossRef] [PubMed]
- Demarchis, F.; Pompa, A.; Bellucci, M. Plastid Proteostasis and Heterologous Protein Accumulation in Transplastomic Plants. Plant Physiol. 2012, 160, 571–581. [Google Scholar] [CrossRef]
- Wang, K.; Gao, Z.; Wang, Y.; Meng, C.; Li, J.; Qin, S.; Cui, Y. The chloroplast genetic engineering of a unicellular green alga Chlorella vulgaris with two foreign peptides co-expression. Algal Res. 2021, 54, 102214. [Google Scholar] [CrossRef]
- Daniell, H.; Lee, S.-B.; Grevich, J.; Saski, C.; Quesada-Vargas, T.; Guda, C.; Tomkins, J.; Jansen, R.K. Complete chloroplast genome sequences of Solanum bulbocastanum, Solanum lycopersicum and comparative analyses with other Solanaceae genomes. Theor. Appl. Genet. 2006, 112, 1503–1518. [Google Scholar] [CrossRef]
- Wang, K.; Cui, Y.; Wang, Y.; Gao, Z.; Liu, T.; Meng, C.; Qin, S. Chloroplast Genetic Engineering of a Unicellular Green Alga Haematococcus pluvialis with Expression of an Antimicrobial Peptide. Mar. Biotechnol. 2020, 22, 572–580. [Google Scholar] [CrossRef] [PubMed]
- Bo, Y.; Wang, K.; Wu, Y.; Cao, H.; Cui, Y.; Wang, L. Establishment of a chloroplast transformation system in Tisochrysis lutea. J. Appl. Phycol. 2020, 32, 2959–2965. [Google Scholar] [CrossRef]
- Cui, Y.; Wang, J.; Jiang, P.; Bian, S.; Qin, S. Transformation of Platymonas (Tetraselmis) subcordiformis (Prasinophyceae, Chlorophyta) by agitation with glass beads. World J. Microbiol. Biotechnol. 2010, 26, 1653–1657. [Google Scholar] [CrossRef]
- Narra, M.; Kota, S.; Velivela, Y.; Ellendula, R.; Allini, V.R.; Abbagani, S. Construction of chloroplast transformation vector and its functional evaluation in Momordica charantia L. 3 Biotech 2018, 8, 140. [Google Scholar] [CrossRef] [PubMed]
- Verma, D.; Daniell, H. Chloroplast Vector Systems for Biotechnology Applications. Plant Physiol. 2007, 145, 1129–1143. [Google Scholar] [CrossRef] [PubMed]
- Cui, Y.; Jiang, P.; Wang, J.; Li, F.; Chen, Y.; Zheng, G.; Qin, S. Genetic transformation of Platymonas (Tetraselmis) subcordiformis (Prasinophyceae, Chlorophyta) using particle bombardment and glass-bead agitation. Chin. J. Oceanol. Limnol. 2011, 30, 471–475. [Google Scholar] [CrossRef]
- Rasala, B.A.; Muto, M.; Sullivan, J.; Mayfield, S.P. Improved heterologous protein expression in the chloroplast of Chlamydomonas reinhardtii through promoter and 5′ untranslated region optimization. Plant Biotechnol. J. 2011, 9, 674–683. [Google Scholar] [CrossRef] [PubMed]
- Manuell, A.L.; Beligni, M.V.; Elder, J.H.; Siefker, D.T.; Tran, M.; Weber, A.; McDonald, T.L.; Mayfield, S.P. Robust expression of a bioactive mammalian protein in Chlamydomonas chloroplast. Plant Biotechnol. J. 2007, 5, 402–412. [Google Scholar] [CrossRef]
- Surzycki, R.; Greenham, K.; Kitayama, K.; Dibal, F.; Wagner, R.; Rochaix, J.-D.; Ajam, T.; Surzycki, S. Factors effecting expression of vaccines in microalgae. Biologicals 2009, 37, 133–138. [Google Scholar] [CrossRef]
- Rasala, B.A.; Muto, M.; Lee, P.A.; Jager, M.; Cardoso, R.M.; Behnke, C.A.; Kirk, P.; Hokanson, C.A.; Crea, R.; Mendez, M.; et al. Production of therapeutic proteins in algae, analysis of expression of seven human proteins in the chloroplast of Chlamydomonas reinhardtii. Plant Biotechnol. J. 2010, 8, 719–733. [Google Scholar] [CrossRef]
- Ruhlman, T.; Verma, D.; Samson, N.; Daniell, H. The Role of Heterologous Chloroplast Sequence Elements in Transgene Integration and Expression. Plant Physiol. 2010, 152, 2088–2104. [Google Scholar] [CrossRef]
- Purton, S.; Szaub, J.B.; Wannathong, T.; Young, R.; Economou, C.K. Genetic engineering of algal chloroplasts: Progress and prospects. Russ. J. Plant Physiol. 2013, 60, 491–499. [Google Scholar] [CrossRef]
- Wibowo, D.; Zhao, C.-X. Recent achievements and perspectives for large-scale recombinant production of antimicrobial peptides. Appl. Microbiol. Biotechnol. 2018, 103, 659–671. [Google Scholar] [CrossRef]
- Zhang, Y.; Teng, D.; Mao, R.; Wang, X.; Xi, D.; Hu, X.; Wang, J. High expression of a plectasin-derived peptide NZ2114 in Pichia pastoris and its pharmacodynamics, postantibiotic and synergy against Staphylococcus aureus. Appl. Microbiol. Biotechnol. 2013, 98, 681–694. [Google Scholar] [CrossRef] [PubMed]
- Ansari, F.A.; Guldhe, A.; Gupta, S.K.; Rawat, I.; Bux, F. Improving the feasibility of aquaculture feed by using microalgae. Environ. Sci. Pollut. Res. 2021, 28, 43234–43257. [Google Scholar] [CrossRef]
- Dong, B.; Cheng, R.-Q.; Liu, Q.-Y.; Wang, J.; Fan, Z.-C. Multimer of the antimicrobial peptide Mytichitin-A expressed in Chlamydomonas reinhardtii exerts a broader antibacterial spectrum and increased potency. J. Biosci. Bioeng. 2018, 125, 175–179. [Google Scholar] [CrossRef]
- Lanh, P.T.; Nguyen, H.M.; Duong, B.T.T.; Hoa, N.T.; Thom, L.T.; Tam, L.T.; Thu, H.T.; Van Nha, V.; Hong, D.D.; Mouradov, A.; et al. Generation of microalga Chlamydomonas reinhardtii expressing VP28 protein as oral vaccine candidate for shrimps against White Spot Syndrome Virus (WSSV) infection. Aquaculture 2021, 540, 736737. [Google Scholar] [CrossRef]
- Hao, T.-B.; Yang, Y.-F.; Balamurugan, S.; Li, D.-W.; Yang, W.-D.; Li, H.-Y. Enrichment of f/2 medium hyperaccumulates biomass and bioactive compounds in the diatom Phaeodactylum tricornutum. Algal Res. 2020, 47, 101872. [Google Scholar] [CrossRef]
- Jiang, P. Expression of hepatitis B surface antigen gene (HBsAg) in Laminaria japonica (Laminariales, Phaeophyta). Chin. Sci. Bull. 2002, 47, 1438. [Google Scholar] [CrossRef]
- Wei, S.; Xu, P.; Yao, Z.; Cui, X.; Lei, X.; Li, L.; Dong, Y.; Zhu, W.; Guo, R.; Cheng, B. A composite hydrogel with co-delivery of antimicrobial peptides and platelet-rich plasma to enhance healing of infected wounds in diabetes. Acta Biomater. 2021, 124, 205–218. [Google Scholar] [CrossRef]

| Diameter of the Inhibition Circles of Antibiotic (mm) | Diameter of the Inhibition Circles of AMPs (mm) | |
|---|---|---|
| Staphylococcus aureus | 17.03 ± 0.03 | 17.52 ± 0.34 |
| Vibrio parahaemolyticus | 14.88 ± 0.74 | 15.96 ± 0.45 |
| Primers | Sequences (5′-3′) | Special Sequences | Target Gene |
|---|---|---|---|
| 16S-for | TATCCGGAATCACTGGGCGTAA | 16S rDNA | |
| 16S-rev | TTTAAGGAGGTGATCCAGCCGC | 16S rDNA | |
| TrnA-for | AAGGGGATATAGCTCAGTTGG | trnA-23S rDNA | |
| TrnA-rev | GGAGAACCAGCTAGCTCCGGAT | trnA-23S rDNA | |
| PpsbA-for | CATCAACTTTATCTAAAGACGA | psbA promoter | |
| PpsbA-rev | AATTTTTTTGTTAAATAAAAGTTTTTTGTG | psbA promoter | |
| PpsbB-for | CTGTATTGTAGTTTTTTTTAATA | psbB promoter | |
| PpsbB-rev | TAATTACTACAATTAGAATTAAACTC | psbB promoter | |
| TatpA-for | TCAATAATTAATATTTATAGTGTTCA | atpA terminator | |
| TatpA-rev | CTGCTATTTTACTTATCACTCATTA | atpA terminator | |
| TpsbA-for | GATTTATAAAAAACAAAAAAGCACTTC | psbA terminator | |
| TpsbA-rev | ACTAGGTGTCCCTATTATTGGTATG | psbA terminator | |
| bar-for | ATGAGCCCAGAACGACGCC | bar | |
| bar-rev | TCATCAAATCTCGGTGACGGG | bar | |
| P1-for | GGCTGGATCACCTCCTTAAACATCAACTTTATCTAAAGACGA | psbA promoter | |
| P1-rev | GGCGTCGTTCTGGGCTCATGAATTTTTTTGTTAAATAAAAGTTTTTTGTG | psbA promoter | |
| P2-for | CCCGTCACCGAGATTTGATGATCAATAATTAATATTTATAGTGTTCA | atpA terminator | |
| P2-rev | TCTAGAGGTATTAAAAAAAACTACAATACAGTCAATAATTAATATTTATAGTGTTCA | XbaI | atpA terminator |
| P3-for | CGAGCTCGATTTATAAAAAACAAAAAAGCACTTC | psbB promoter | |
| P3-rev | CCAACTGAGCTATATCCCCTTACTAGGTGTCCCTATTATTGGTAT | psbB promoter | |
| P4-for | AAGGGGATATAGCTCAGTTGG | psbA terminator | |
| P4-rev | GGAATCCGGAGAACCAGCTAGCTCCGGAT | psbA terminator | |
| T1-for | CCTCTAGAATGCATCATCACCATCACCATGGTTTCGGTTGCAACGGTCCCTGG | XbaI, 6 × His | ant1 |
| T1-rev | TTAGTAGCACTTGCAGACGAAAATAAATTATCCTTATGAAATGGTGATGGTGATGGTGCAT | RBS | ant1 |
| T2-for | ATGCACCATCACCATCACCATTTCTTCTTCCACATCATCAAGGG | 6 × His | ant2 |
| T2-rev | GGGATCCTTACTTCCAGACGAGACCGTGGAT | BamHI | ant2 |
| con-F for | AGCATCGGCTAACTCCGTGC | 16S rDNA-trnA-23S | |
| con-F rev | TAACCGCTGCGCCTCAACGC | 16S rDNA-trnA-23S |
Publisher’s Note: MDPI stays neutral with regard to jurisdictional claims in published maps and institutional affiliations. |
© 2022 by the authors. Licensee MDPI, Basel, Switzerland. This article is an open access article distributed under the terms and conditions of the Creative Commons Attribution (CC BY) license (https://creativecommons.org/licenses/by/4.0/).
Share and Cite
Han, S.; Zhao, J.; Liu, P.; Wang, K.; Qin, S.; Zhao, Z.; Cui, Y. Two Foreign Antimicrobial Peptides Expressed in the Chloroplast of Porphyridium purpureum Possessed Antibacterial Properties. Mar. Drugs 2022, 20, 484. https://doi.org/10.3390/md20080484
Han S, Zhao J, Liu P, Wang K, Qin S, Zhao Z, Cui Y. Two Foreign Antimicrobial Peptides Expressed in the Chloroplast of Porphyridium purpureum Possessed Antibacterial Properties. Marine Drugs. 2022; 20(8):484. https://doi.org/10.3390/md20080484
Chicago/Turabian StyleHan, Subing, Jialin Zhao, Ping Liu, Kang Wang, Song Qin, Zhenjun Zhao, and Yulin Cui. 2022. "Two Foreign Antimicrobial Peptides Expressed in the Chloroplast of Porphyridium purpureum Possessed Antibacterial Properties" Marine Drugs 20, no. 8: 484. https://doi.org/10.3390/md20080484
APA StyleHan, S., Zhao, J., Liu, P., Wang, K., Qin, S., Zhao, Z., & Cui, Y. (2022). Two Foreign Antimicrobial Peptides Expressed in the Chloroplast of Porphyridium purpureum Possessed Antibacterial Properties. Marine Drugs, 20(8), 484. https://doi.org/10.3390/md20080484

